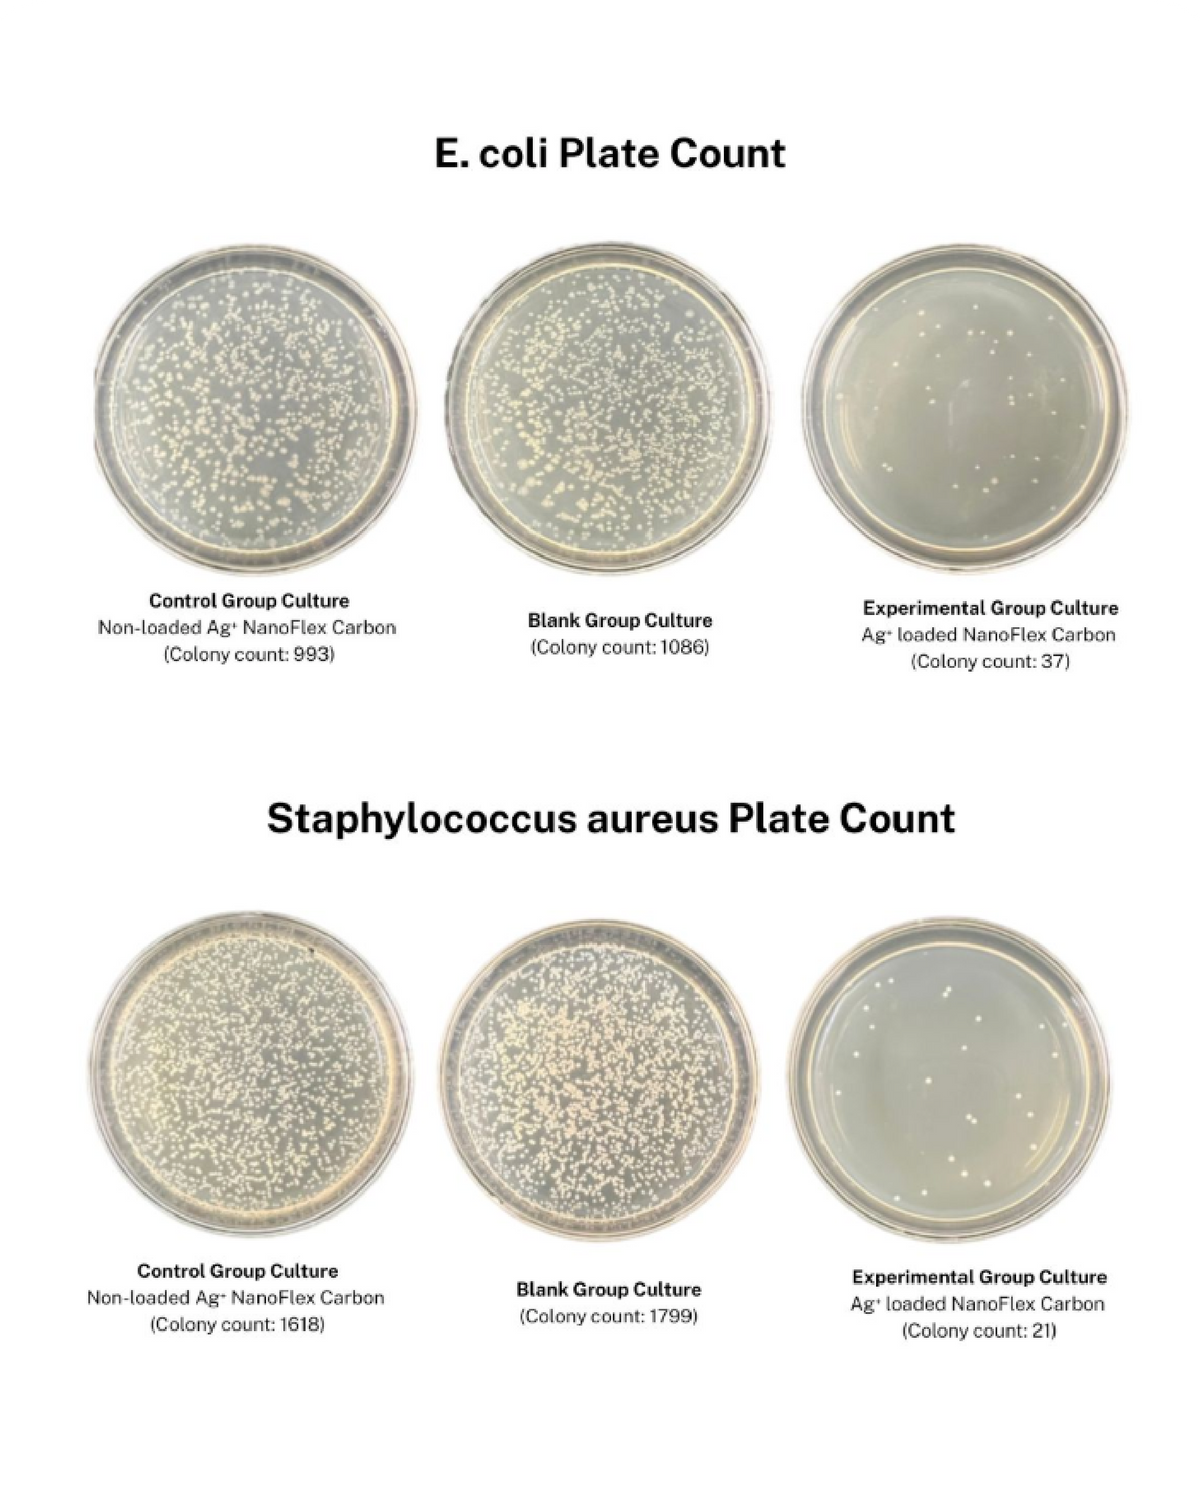
Culture State Colony Count

How it Works
Dual-Stage,
99.999% Purification,
Superior Taste.
Next-generation water purifier, lab-tested for exceptional quality. Powered by NanoFlex Carbon + 0.1 μm micro-membrane for consistently pure and great-tasting water.
Dual Purifier, Ultra Clean,
Superior Taste
Next-generation water purifier, lab-tested for exceptional quality. Powered by NanoFlex Carbon + 0.1 μm micro-membrane for consistently pure and great-tasting water.
Every Sip, Clearly Safer
Backed by OASSAY’s patent-pending NanoFlex Carbon technology, lab-tested and awarded the Geneva Invention Silver, FlexFlow ensures safe, reliable purification with every sip.
▌Tested, Awarded, Trusted by Data. ▌

Geneva Invention Silver Medal Diploma

Antibacterial Performance Test Report
Culture State Colony Count
Trusted by Real Reviews
@The Survival Outpost
"From clean wilderness creeks to the dirtiest urban water sources. Oassay FlexFlow performs in true survival conditions."
@Build The Dream
"I can just put close it up and drink. This is so much better than some sort of straw or anything like that."
@Louie Seddon
"It's lightweight simple to use and built for adventures on the move."
@Outdoors Survival Hub
"It's perfect for bushcraft, camping, hiking, and survival situations."
@Neil Begasa
"Whether it's for hiking, travel, or daily use, this bottle is designed to go where you go."
@Chloe
"This OASSAY bottle allows you to drink water from ANYWHERE!"
